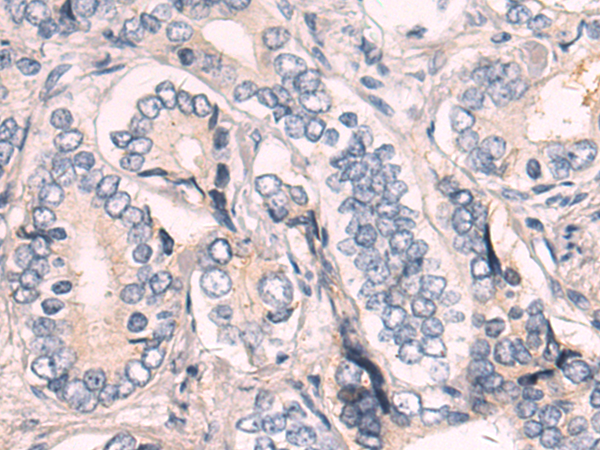

-
分类: 科研抗体货号: P11004别名: LIG1; LIG-1应用: WB,IHC反应种属: Human, Mouse
-
分类: 科研抗体货号: P11003别名: RYA3, LPLUNC3, C20orf185, dJ726C3.4应用: WB,IHC反应种属: Human
-
分类: 科研抗体货号: P11002别名: RYSR, BPIL1, LPLUNC2, C20orf184, dJ726C3.2应用: IHC反应种属: Human, Mouse
-
分类: 科研抗体货号: P11019别名: MCT14应用: WB,IHC反应种属: Human, Mouse
-
分类: 科研抗体货号: P11001别名: LAMA, S-LAM-alpha应用: IHC反应种属: Human
-
分类: 科研抗体货号: P11017别名: MC2应用: WB反应种属: Human, Mouse
-
分类: 科研抗体货号: P11000别名: MDS, LIS1, LIS2, MDCR, PAFAH应用: IHC反应种属: Human, Mouse, Rat
-
分类: 科研抗体货号: P11016别名:应用: IHC反应种属: Human, Mouse
-
分类: 科研抗体货号: P10999别名: SWS; SJS2; STWS; CD118; LIF-R应用: IHC反应种属: Human
-
分类: 科研抗体货号: P11015别名: CMM5, MSH-R, SHEP2应用: IHC反应种属: Human, Mouse

鄂公网安备42018502007531号
鄂公网安备42018502007531号

